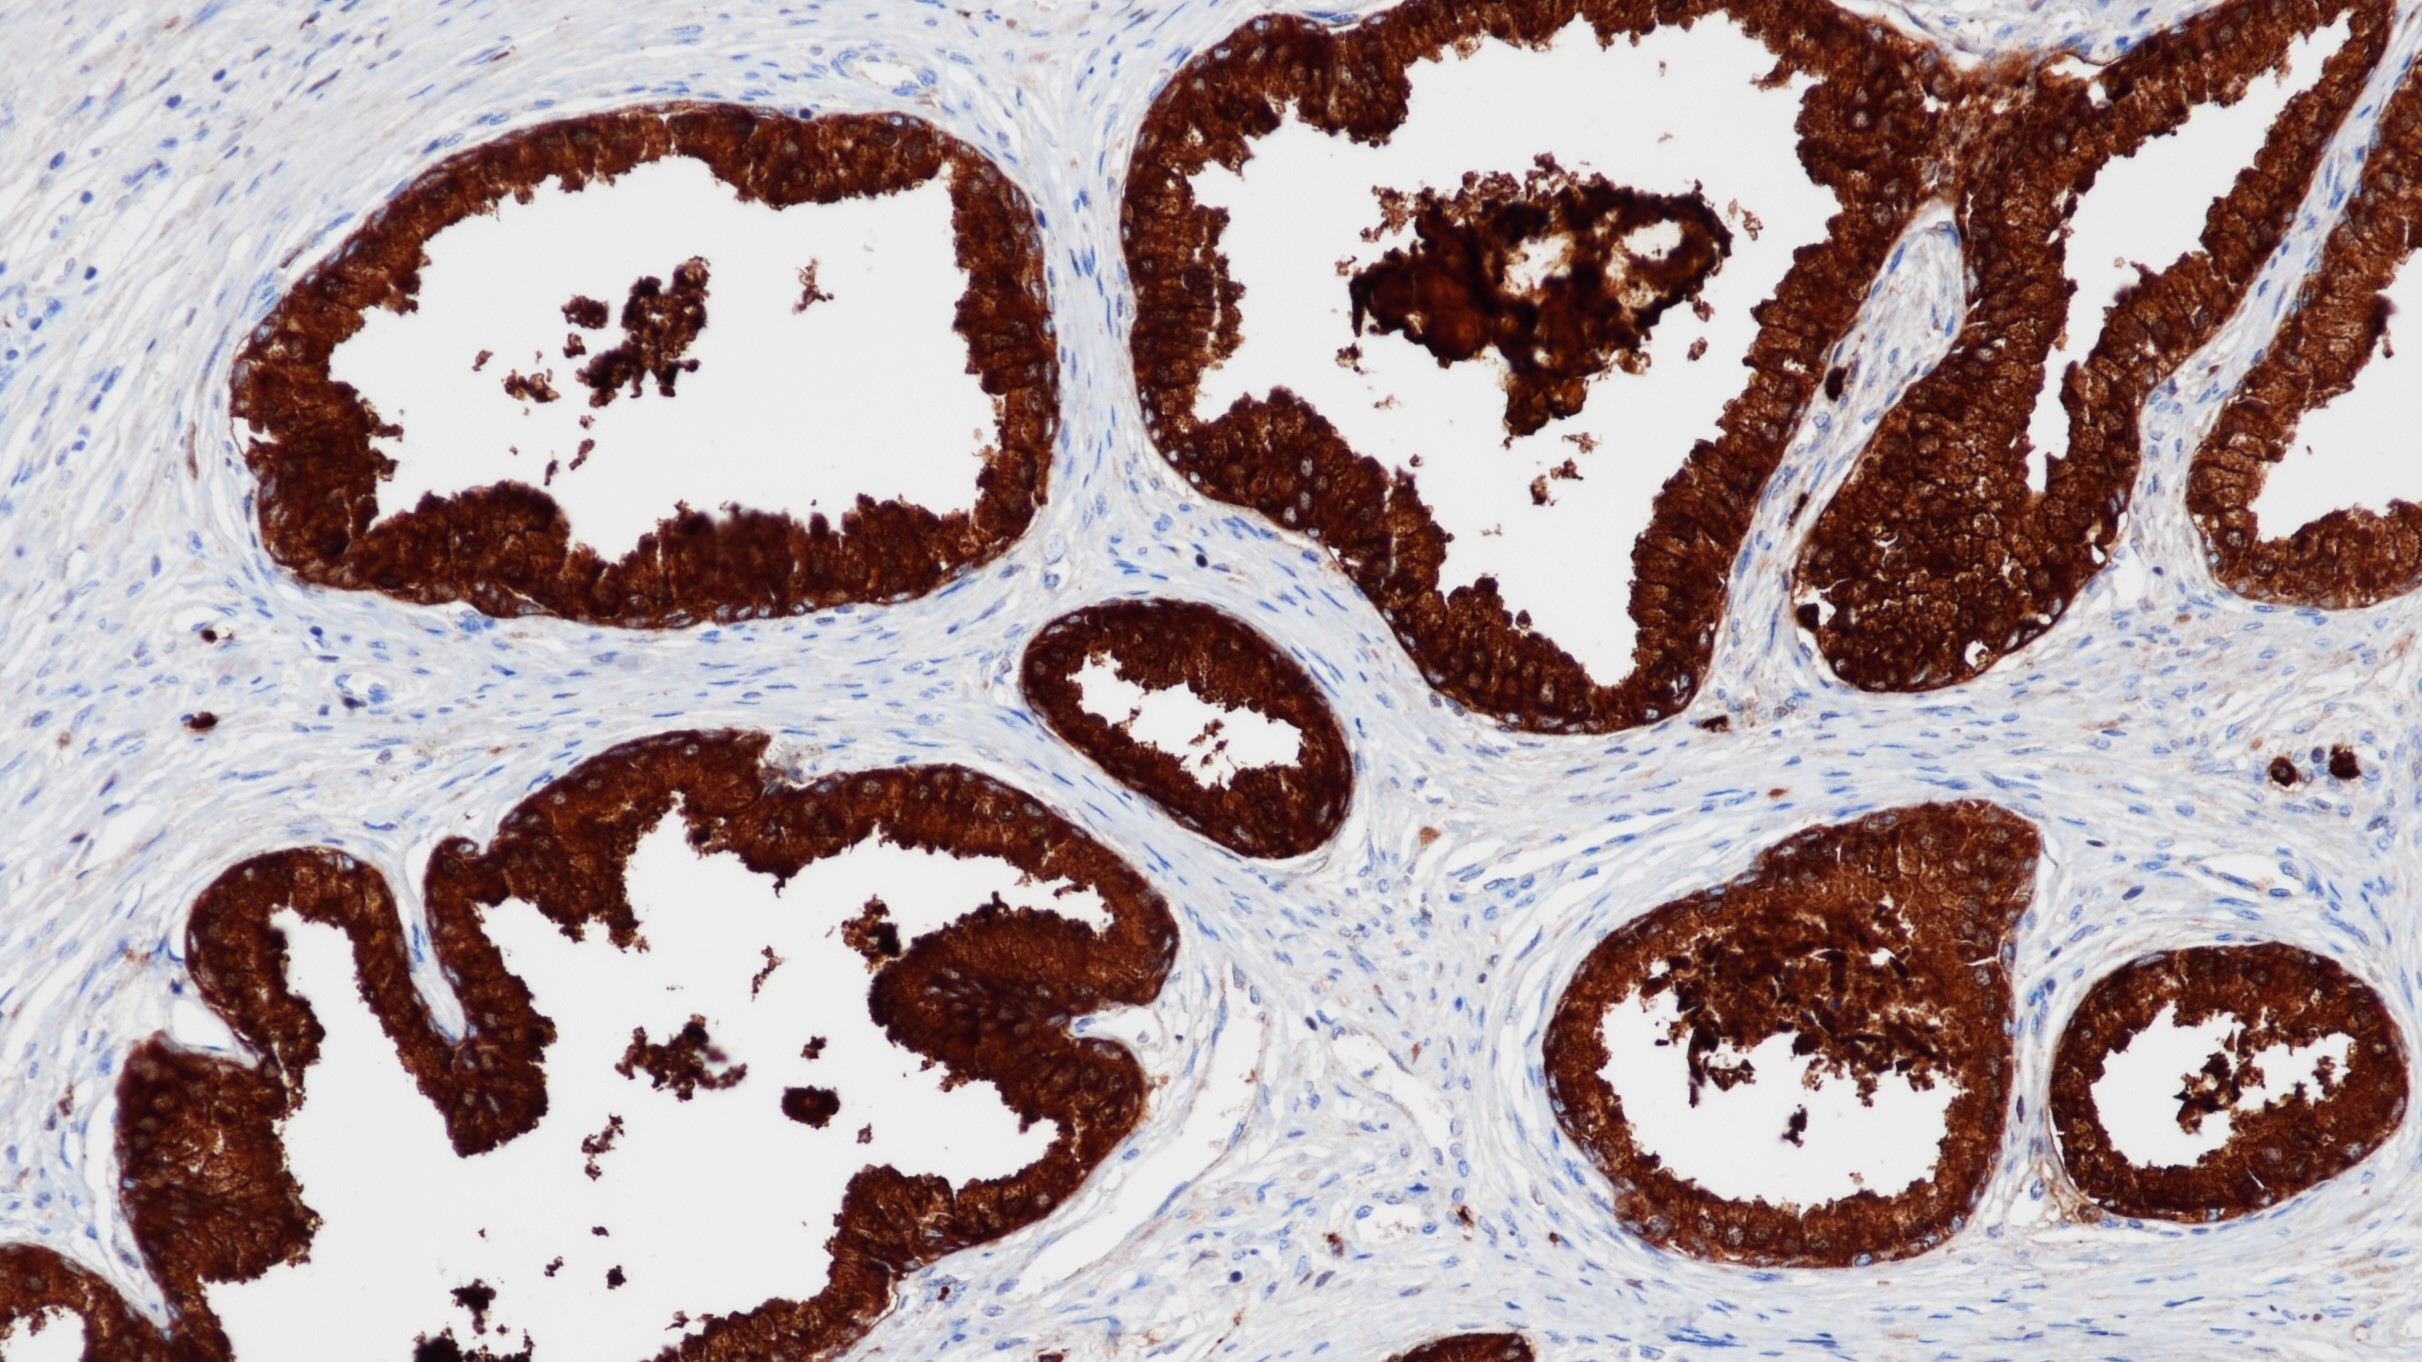
前列腺PSA(BP6043)染色

1. Stenman, U-H et al. Prostate-specific antigen. Cancer Biol 1999; 9:83-93.
2. Alanen, KA et al. Immunohistochemical labelling for prostate specific antigen in non prostatic tissues. Path Res Pract 1996; 192:233-237.
3. 中华医学会.《临床技术操作规范·病理学分册》.人民军医出版社,2004.